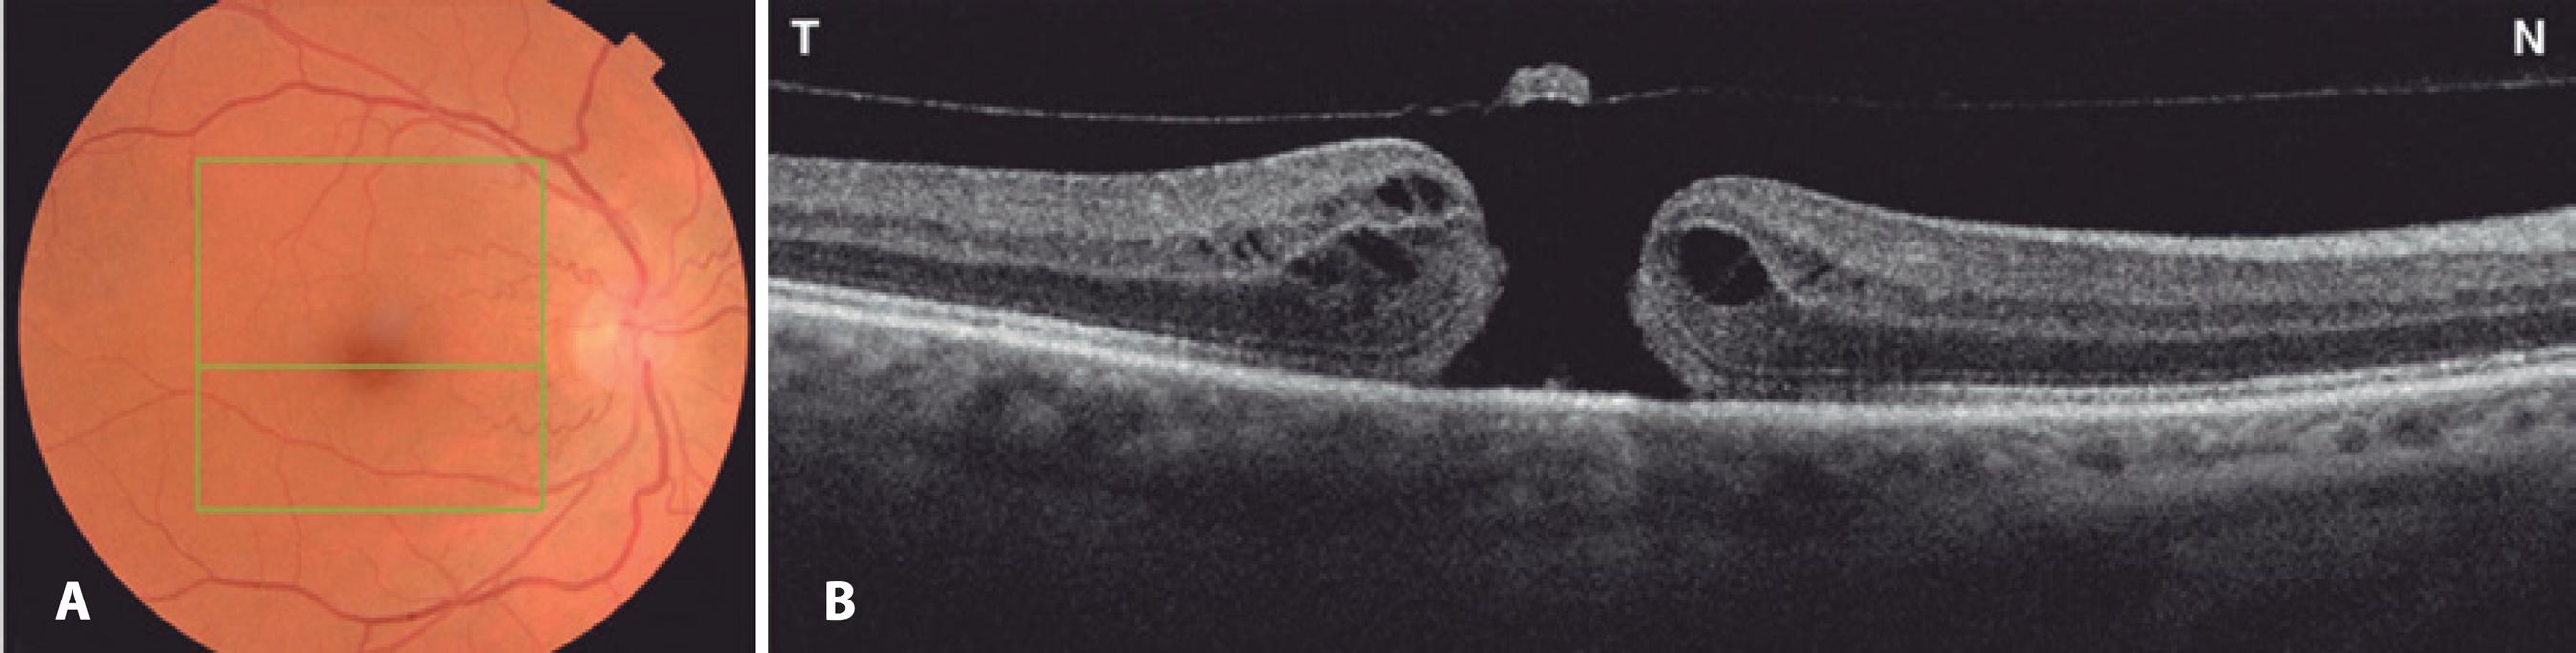

INTRODUCTION
Pars plana vitrectomy (PPV) with perimacular traction removal and facedown intraocular gas tamponade have demonstrated utility in treating idiopathic full-thickness macular holes (FTMH). Despite great advances in surgical technique over the last few years with the achievement of good anatomical and functional outcomes, FTMH surgical treatment remains associated with a number of ocular complications, including retinal detachment, retinal tears, enlargement of the hole, macular phototoxicity, postoperative intraocular pressure (IOP) elevation, and cataracts(1,2). Furthermore, visual field (VF) defects associated with peripapillary retinal nerve fiber layer (RNFL) thickness reduction, optic neuropathy, and optic disc pallor may occur after otherwise uncomplicated surgery for macular hole treatment. Although various underlying mechanisms, including optic nerve and retinal ischemia, have been proposed, the exact cause remains unclear(3-5). Visual loss from optic neuropathy following uncomplicated PPV for idiopathic FTMH treatment is a rare and potentially devastating complication(3,5,6). Previous studies(5) have been unable to fully elucidate the mechanisms underlying visual loss, with only one study documenting the occurrence of nonarteritic anterior ischemic optic neuropathy (NAION) following uncomplicated PPV. The exact incidence of NAION, however, may be underestimated as optic disc evaluations are usually impaired by the presence of intraocular gas during the early postoperative period.
Here, we aimed to report the incidence of NAION following uneventful PPV for idiopathic FTMH treatment and discuss the potential mechanisms underlying this serious postoperative complication.
CASE REPORT
A 56-year-old previously healthy woman reported a 6-month history of progressive visual decline in her right eye (OD). Her past medical history was unremarkable, with no history of stroke, myocardial infarction, dyslipidemia, sleep apnea syndrome, or smoking. Best-corrected visual acuity (VA) was 20/200 in OD, 20/20 in the left eye (OS). Slit lamp examination was normal; the patient was phakic, and the anterior chamber angle was wide open in both eyes on gonioscopy. IOP was 18 mmHg in OD and 19 mmHg in OS. Fundus examination revealed normal optic nerves with a cup-to-disc ratio of 0.2, partial posterior vitreous detachment, and a macular hole in OD (Figure 1 A), and was normal in OS. Optical coherence tomography (OCT) showed a full-thickness macular hole with overlying operculum (Figure 1 B). Under retrobulbar anesthesia, she underwent an uneventful 25-gauge posterior PPV with posterior hyaloid separation followed by internal limiting membrane (ILM) staining with brilliant blue G (Ophthalmos™, Brazil) for 30 s. Subsequently, intraocular forceps were used to circumferentially peel ILM around the macular hole. A few self-limited, small, superficial, pre-retinal hemorrhages occurred in the peeled macular area. Then, fluid-air exchange and air-gas exchange with 20% SF6 were performed. No hyper- or hypotensive events were observed intraoperatively. The patient was instructed to maintain a face-down position for 5 days postoperatively.
Figure 1 A) Preoperative fundus retinography demonstrating normal optic nerves with a small cup-to-disc ratio and macular hole affecting the right eye. The green square represents the area of the macular hole (6 × 6 mm) on optical coherence tomography (OCT). The central green horizontal line represents the OCT scan through the center of the fovea. B) OCT (horizontal scan) of the same eye demonstrating a full-thickness macular hole with overlying operculum.
The initial postoperative VA was 20/400, with an IOP of 10 mmHg in the operative eye. On the fifth postoperative day, the patient noticed sudden painless vision loss, with the VA reduced to finger counting at 1 meter in OD. On examination, she had a right relative afferent pupillary defect with an IOP of 29 mmHg in OD. Her right optic nerve was edematous (Figure 2 A). OCT imaging of the macular area revealed macular hole closure (Figure 2 B). Automated perimetry was obtained on the 14th post-operative day and demonstrated a diffuse reduction of sensitivity with an inferior altitudinal defect (Figure 3). The erythrocyte sedimentation rate (ESR) was 20 mm/h, C-reactive protein (CRP) was <0.3 mg/l, and the patient denied any symptoms suggestive of giant cell arteritis (GCA). A fixed combination of timolol maleate 0.5% and brimonidine tartrate 0.2% (Combigan®) twice daily for OD was initiated in combination with 80 mg of prednisone orally for 7 days with subsequent dose tapering. Three months later, the best-corrected visual acuity was 20/160-1O D. The right optic nerve was pale, and the macular hole remained closed (Figure 4).

Figure 2 A) Fundus retinography demonstrating optic disc edema affecting the right eye 7 days after surgery. B) Fundus retinography of same eye. C) Optical coherence tomography (horizontal scan) demonstrating complete closure of the macular hole.

Figure 3 Automated Humphrey visual field (24-2) of the right eye, 14 days after the procedure, revealing diffuse depression and an inferior altitudinal defect that was more pronounced in the inferior nasal quadrant.
DISCUSSION
NAION is the most common optic neuropathy in patients >50 years old; it is thought to be a multifactorial disease involving an ischemic process resulting from microvascular occlusion or hypoperfusion of the blood supply to the optic nerve head, resulting in sudden visual loss associated with pale optic disc edema.
Taban et al. described two cases of NAION after uncomplicated vitrectomy for macular hole and epiretinal membrane(6): A 65-year-old phakic hypertensive and diabetic woman and a 94-year-old aphakic hypertensive man. Both patients developed sudden visual loss and optic disc edema in the operated eye approximately 1 month after vitrectomy, with NAION subsequently diagnosed. The present case differs because the patient was younger and had no systemic risk factors such as hypertension or diabetes mellitus. Furthermore, she presented with visual loss soon after surgery, which reinforces the role of PPV in the development of NAION.
More recently, Bansal et al. retrospectively reviewed 7 patients who underwent PPV for primary regmatogenous retinal detachment with subsequent development of optic neuropathy, with comparison to 42 age- and gender-matched patients undergoing similar surgery. Despite the apparent lack of structural findings early in the postoperative period, all 7 patients eventually developed optic nerve pallor, a relative afferent pupillary defect, and VF defects. The authors further performed a review of 37 previously reported eyes with VF defect after PPV and found that none had documented disc edema despite the authors positing ischemia as a potential cause. While the authors indicated that the presence of an intraocular gas bubble precluded a detailed assessment of the optic nerve head during the postoperative period, they postulated that post-vitrectomy optic neuropathies are more consistent with posterior ischemic optic neuropathy, similar to those seen after spine surgery(5). The present case in addition to those described by Bansal et al.(5) indicate that optic neuropathy with optic disc edema (anterior ischemic optic neuropathy) may, in fact, occur. Furthermore, we agree with Taban et al.(6) that visibility is difficult early during the post-operative period due to the presence of an intraocular gas bubble. Accordingly, the occurrence of optic disc edema may be an under-reported phenomenon.
While the exact mechanisms underlying the development of optic neuropathy after PPV have yet to be fully elucidated, a combination of factors may have contributed to the occurrence of NAION after posterior vitrectomy in the present case. We believe the combination of face-down position and increased IOP during the postoperative period of macular hole surgery may play an important role in the development of NAION(7). One possible explanation is that the blood flow to the optic nerve head, which is dependent on perfusion pressure, may have been impaired. Ocular perfusion pressure is the difference between mean arterial blood pressure and IOP or venous pressure. Since both IOP and venous pressure are increased in the prone position, the combination of these two events may precipitate ischemia of the anterior portion of the optic nerve, resulting in NAION. Although we documented only a moderate increase in IOP in the present case, IOP may have reached a much higher level before examination and thereby contributed to the development of NAION(8). The association between face-down position and increased IOP is well described, notably in low-light conditions, and can be used in clinical practice as a provocative test for angle-closure glaucoma(7). The exact mechanism underlying IOP elevation is not completely understood, but it may be related to forward movement of the lens in the prone position, particularly when associated with mydriasis, possibly leading to anterior chamber angle closure and impaired aqueous humor out-flow. Therefore, we believe a combination of such factors may have contributed to IOP elevation in the present case.
Other factors may contribute to the occurrence of NAION after vitreoretinal surgery, e.g., posterior vitreous detachment, indicating that direct mechanical trauma to the optic disc during separation of the posterior hyaloid may lead to damage to the retinal arterioles, nerve fiber layer, or retina(6,9). Parsa and Hoyt posited that the vitreous adhesion over the optic disc and peripapillary retina may be particularly strong over the cupless disc, with stretching and elongation during posterior vitreous detachment breaking the cytoskeleton in older and less distensible axons, leading to axoplasmic accumulation and axonal atrophy in the prelaminar sites of separation(9). In the present case, the posterior hyaloid was adhered to the peripapillary area, indicating the traction induced during aspiration of the posterior cortical vitreous may have resulted in axonal damage. However, this is less likely as visual loss was present on the first and not the fifth postoperative day in the present case.
Another possible explanation for NAION after macular hole repair is indirect mechanical trauma induced by high infusion pressure during air-fluid exchange. However, in our patient, a system that constantly monitors air pressure infusion was used (The Constellation® Vision System, Alcon Laboratories) and the target pressure was set at 30 mmHg, which is the standard for the majority of vitrectomy surgeries, making this hypothesis less feasible. Indeed, Hirata et al. demonstrated that reduced air pressure infusion to 30 mmHg decreased the incidence of VF defects after macular hole surgery from 24% to 4%(10).
Bansal et al. posited that reduced ocular perfusion due to intraoperative systemic hypotension may be a risk factor for the development of optic neuropathy after PPV(5). That explanation, however, is also difficult to reconcile with the findings of the present case as visual loss clearly developed within 5 days of surgery. A final possibility is that the occurrence of NAION in the present case may have been a coincidental event unrelated to surgery asNAION is the most common optic neuropathy in patients in the sixth decade of life. However, we consider this possibility s very unlikely.
In conclusion, we believe the combination of face-down positioning and increased IOP with other risk factors, such as a small optic disc cup, may have predisposed the present case to NAION after apparently uneventful posterior vitrectomy for macular hole treatment. Vitreoretinal surgeons should be aware of this potentially serious complication and recognize its risk factors and clinical findings.

English PDF
Print
Send this article by email
How to cite this article
Submit a comment
Mendeley
Scielo
Pocket
Share on Linkedin

